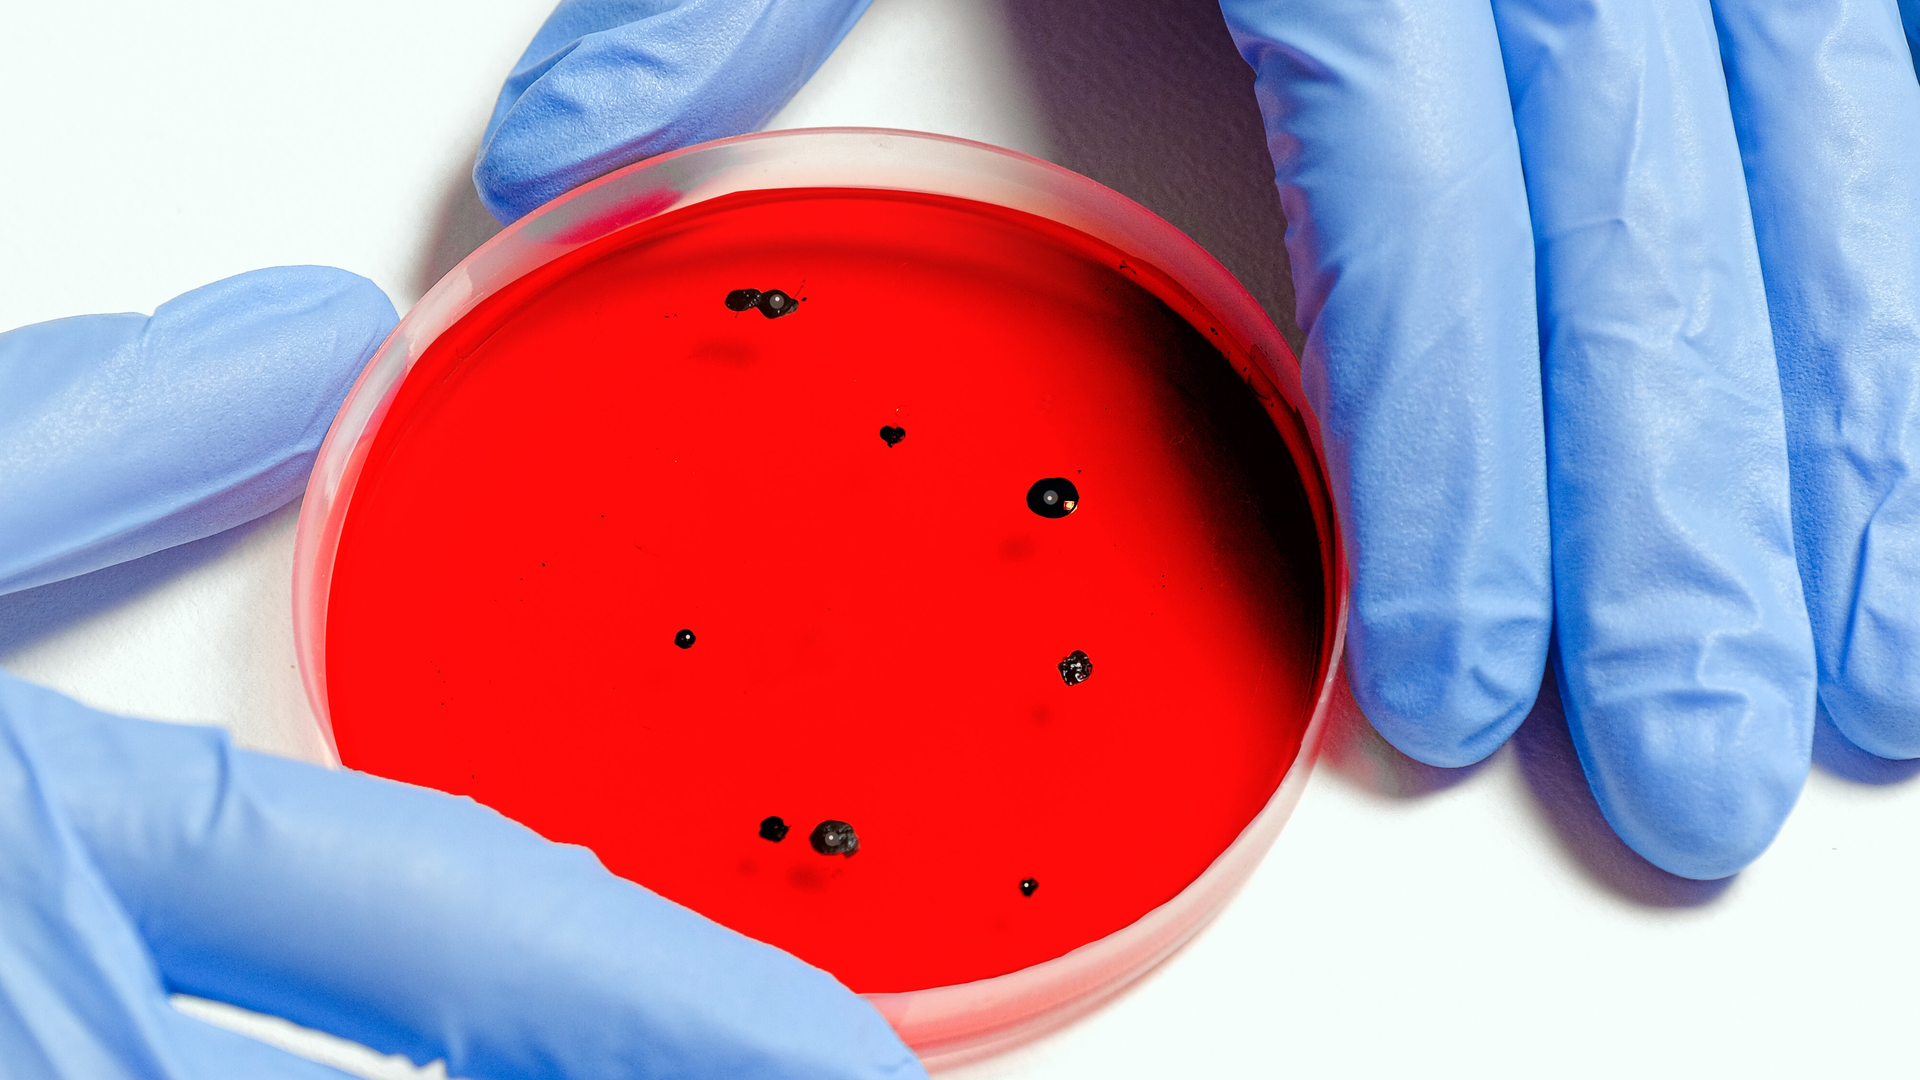
Pexels Anna Shvets 3786247 5f7dcb74eb19d
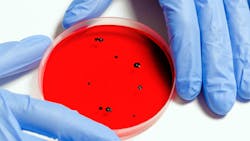
Pexels Anna Shvets 3786247 5f7dcb74eb19d Pexels Anna Shvets 3786247 5f7dcb74eb19d

Welcome to the October 2020 issue of WaterWorld. For our cover story this month, I spoke with the Water Research Foundation and employees at the University of Arizona and Miami-Dade Water and Sewer Department about efforts to track the coronavirus in wastewater sampling. Though municipalities have used sewage surveillance for years to track antibiotic and opioid use, the pandemic marks the first time a coordinated effort has been undertaken to measure levels of a disease in a community.
With nearly 80 percent of United States households connected to municipal sewage collection systems, this testing could have an enormous impact on what researchers can learn about the virus. According to the Centers for Disease Control and Prevention (CDC), “quantitative SARS-CoV-2 measurements in untreated sewage can provide information on changes in total COVID-19 infection in the community [serviced by] that wastewater treatment plant.”
Wastewater has a story to tell, but as you will read on page 8, there is still some work to be done before a national – or international – standard of testing and communication efforts can be implemented.
Next, on page 10, author Brian Smith discusses how a centralized communication tool, equipped with GIS functionality provided Pennsylvania’s Lehigh County Authority with live field updates, direct integration with other applications, and accurate, high-speed communication. With a new communication system, the utility estimates they have saved almost 800 hours annually by correcting miscommunication with the customer care team and lag time from field to office to complete reports.
On page 16, another effort of the Water Research Foundation is highlighted, this time to provide utilities guidance on how to best apply proven technologies and practices to reduce main breaks and water loss. WRF research project No. 4917, “Utilizing Smart Water Networks to Manage Pressure and Flow for Reduction of Water Loss and Pipe Breaks” kicked off in January 2019 with over $1 million in research investment commitment from associations, utilities, and technical providers to explore smart water network (SWN) applications spanning systemwide pressure management, real-time system modeling (Digital Twins), advanced customer metering to influence usage behavior, and high-frequency pressure monitoring to identify transients.
On page 20, we take a look at resistant pathogens — a problem that wastewater treatment facilities must consider in their treatment plans. As author Jon McClean writes, “the new standard in wastewater disinfection technologies needs to be that which can combat these pathogens.”
Finally, with increasing pressure on utility companies to lower their total cost of ownership and high leakage rates, the rapid development of real-time sensing and monitoring technologies for improving early leakage and water quality anomaly detection are an effective way to address these challenges. That’s the message author James Chalmers shares on page 22, writing, “By combining smart monitoring technology with drives and motors, water utility operators can secure pre-emptive asset management optimization and, in the process, drive a significant shift from reactive to real-time monitoring.”
In addition to these great features, we have rounded up a section of new products in the industry as always. I hope you enjoy this issue of WaterWorld as much as I enjoyed putting it together. WW
Thanks for reading!
About the Author

Alanna Maya
Chief Editor
Alanna Maya is a San Diego State University graduate with more than 15 years of experience writing and editing for national publications. She was Chief Editor for WaterWorld magazine, overseeing editorial, web and video content for the flagship publication of Endeavor's Water Group. In addition, she was responsible for Stormwater magazine and the StormCon conference.